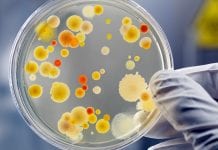

PP Nova Biologicals Related News
Could a pneumonia vaccine be an effective way to prevent the infection?
Pneumonia threatens the lives of our most vulnerable members of society including children and older adults, but the risk of infection can be lessened...
The importance of environmental testing
Nova Biologicals outlines the importance of environmental testing to prevent the spread of harmful bacteria and protect public health.
Among the various forms of microbiological...
Mitigating contamination threats with microbial analysis and water testing
Nova Biologicals, a leading microbiological testing service, outlines how microscopic contaminants can be mitigated and contained through microbial analysis methods such as water testing.
Microscopic...
Essential infection control tips to stay safe this winter
As many of us are spending more time with family and friends, Cameron Medeiros of Nova Biologicals outlines vital infection control measures that can...
Ensuring safe health products with United States Pharmacopeia testing
Microbiological testing specialists Nova Biologicals dissect how United States Pharmacopoeia testing protocols help ensure that medical devices and pharmaceuticals meet the optimal standards for...
Nova Biologicals: Infection prevention during the winter period
Microbiological testing specialist Nova Biologicals outlines the key infection prevention measures to keep in mind this festive season.
The celebration of holidays is one of...
The Environmental Protection Agency: Safeguarding public health
The United States Environmental Protection Agency has a key role to play in ensuring only safe products reach the market, something of increasing importance...
Nova Biologicals: Meeting food safety standards to prevent infection
The experts from microbiological testing specialist Nova Biologicals outline the best ways to uphold food safety standards and prevent bacterial infections.
Food standards
Food safety has...
Nova Biologicals explores travel risks during the COVID-19 pandemic
Nova Biologicals explores the risks of travelling abroad during the COVID-19 pandemic, including the best methods of travel, and the potential of not being...
Nova Biologicals: saving lives with microbiological testing
Nova Biologicals is a Texas based microbiological laboratory focused on providing solutions that save lives, protect life and property, and preserve natural resources.
Since 1993,...
Nova Biologicals explores pathogen contamination in the home
Are viruses, bacteria, or moulds in your home a threat to your family’s health? In this Special Report, Nova Biologicals explores the importance of...
COVID-19 vaccines and the route out of the pandemic
The development and rollout of vaccines against COVID-19 form a key step in the journey towards a post-pandemic world.
For the past year, the coronavirus...
Prisons and COVID-19: benefits of employing microbiological laboratories
Nova Biologicals discusses the benefits of enlisting the help of microbiological laboratories in prisons during the COVID-19 crisis.
Since the COVID-19 pandemic began in the...
Exploring the key findings in environmental hygiene trends
An overview of environmental hygiene trends, challenges, interventions and best practices as found in recent medical literature
Reducing the risk of healthcare-associated infections
Nova Biologicals presents a systematic and proven approach to reducing Clostridium difficile and many other healthcare-associated infections.